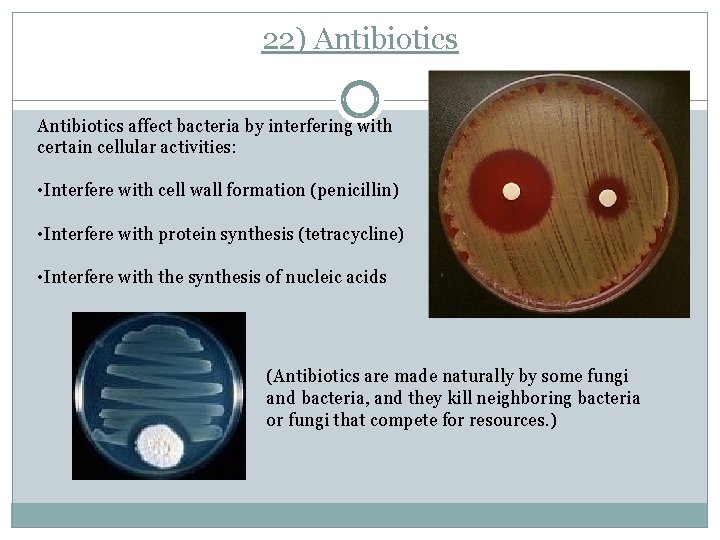
22) Antibiotics affect bacteria by interfering with certain cellular activities: • Interfere with cell

Bacteria 1 Bacteria are the smallest and simplest

Bacteria � 1) Bacteria- are the smallest and simplest organisms on the planet.

2) Characteristics of Bacteria: �Single celled �Lack internal compartmentalization (no membrane bound organelles or nucleus) • Small size- 1 µm to about 5 µms.

Domains � 3) Two major domains: Archaea and Bacteria

Domain: Archaea � 4) Archaea- (means archaic or ancient) �live in extreme environments �cell walls do not contain peptidoglycan �have different lipids in their cell membranes �have different amino acids in their cell walls

Archaeal Groups 5) Methanogens �convert hydrogen gas and carbon dioxide into methane gas �oxygen is poisonous to them (anaerobic) �(live in deep fresh water, marine mud, swamp mud, and sewage, intestinal tracts of organisms such as cows and termites)

Archael Groups � 6) Halophiles- salt-loving archaea �(Live in high salt environments such as, Great Salt Lake, the Dead Sea. )

Archael Groups � 7) Thermoacidophiles- live in very acidic environments that have very high temperatures, such as the hot-springs of Yellowstone National Park. �Up to 230 F �As low as a p. H of 2

8) Domain: Bacteria �Most known prokaryotes are bacteria. �Cell walls contain peptidogylcan

Bacteria Shapes � 9) They occur in many shapes and sizes and have distinct characteristics � Bacilli- Rod shaped � Cocci- round � Spirillia- spiral shaped

10) Bacterial Shapes/Sizes �Strepto- long chains �Staphylo- clusters �Diplo- two

Biology of Prokaryotes 1) Cell Wall- Gives the cell its shape and protects it from toxins 2) Cell Membrane- regulates what goes in and out of the cell 3) DNA- single closed loop of double stranded DNA attached at one point to the cell membrane.

Biology of Prokaryotes 4) Capsules- a covering of polysaccharides protects the cell from harsh chemicals. 5) Pilli- short hair-like protein structures for connections, such as for passage of genetic material between bacteria.

Biology of Prokaryotes 6) Endospores- highly resistant resting structures common to those who may need to wait out some rough times such as • High temperatures • Strong chemicals • Radiation • Drying A Bacillus anthracis endospore (Spores that were dormant for thousands of years in the great tombs of the Egyption Pharohs were able to germinate and grow when placed in appropriate medium. )

Biology of Prokaryotes 7) Plasmidsare small, circular, self replication loops of 2 x stranded DNA.

Nutrition and Metabolism 8) Prokaryotes have two chief nutritional needs: a. a source of carbon to build the organic molecules of their cells b. a source of energy.

Prokaryotic Habitats Prokaryotes live in certain habitats based on their biochemical abilities. 14) Facultative anaerobecan live with or without oxygen. 13) Obligate aerobeneed oxygen to live. 15) Obligate anaerobesorganisms that cannot live where molecular oxygen is present.

Reproduction and Recombination 16) Prokaryotes usually reproduce by binary fission, which is a form of asexual reproduction.

Reproduction and Recombination 17) Conjugation- when two prokaryotes bind together and transfer DNA through a pilus.

Reproduction and Recombination 18) Transduction- a virus takes in prokaryote DNA, makes copies of it AND its own DNA, and then carries bacterial DNA to other cells. 19) Transformation- when a prokaryote takes in DNA from its outside environment.

Bacteria and Humans 20) Pathogensbacteria and other organisms that cause disease.

21) Bacteria cause disease in two ways: Secreting toxins and destroying body tissues. Secreting toxins Toxin-is a poisonous substance produced by living cells or organisms. Destroying bodily tissue As bacteria stick to body cells, they secrete digestive enzymes that break down tissue for its nutritional value, which allows further bacterial invasion.
22) Antibiotics affect bacteria by interfering with certain cellular activities: • Interfere with cell wall formation (penicillin) • Interfere with protein synthesis (tetracycline) • Interfere with the synthesis of nucleic acids (Antibiotics are made naturally by some fungi and bacteria, and they kill neighboring bacteria or fungi that compete for resources. )

23) Antibiotic Resistance Antibiotic resistance- the evolution of populations of pathogenic bacteria that antibiotics are unable to kill. Antibiotic resistance may develop in different ways: Mutations in bacterial DNA may give them resistance to antibiotics Over-prescription and misuse of antibiotics can allow for the development of resistant mutants

MRSA Videos �http: //www. bing. com/videos/search? q=mrsa&view =detail&mid=D 6406 F 9954849 AD 43 A 19 D 6406 F 995 4849 AD 43 A 19&first=21 �http: //www. bing. com/videos/search? q=mrsa&view =detail&mid=343 DF 4 CDB 17486490 BDB 343 DF 4 CD B 17486490 BDB&first=0
- Slides: 24